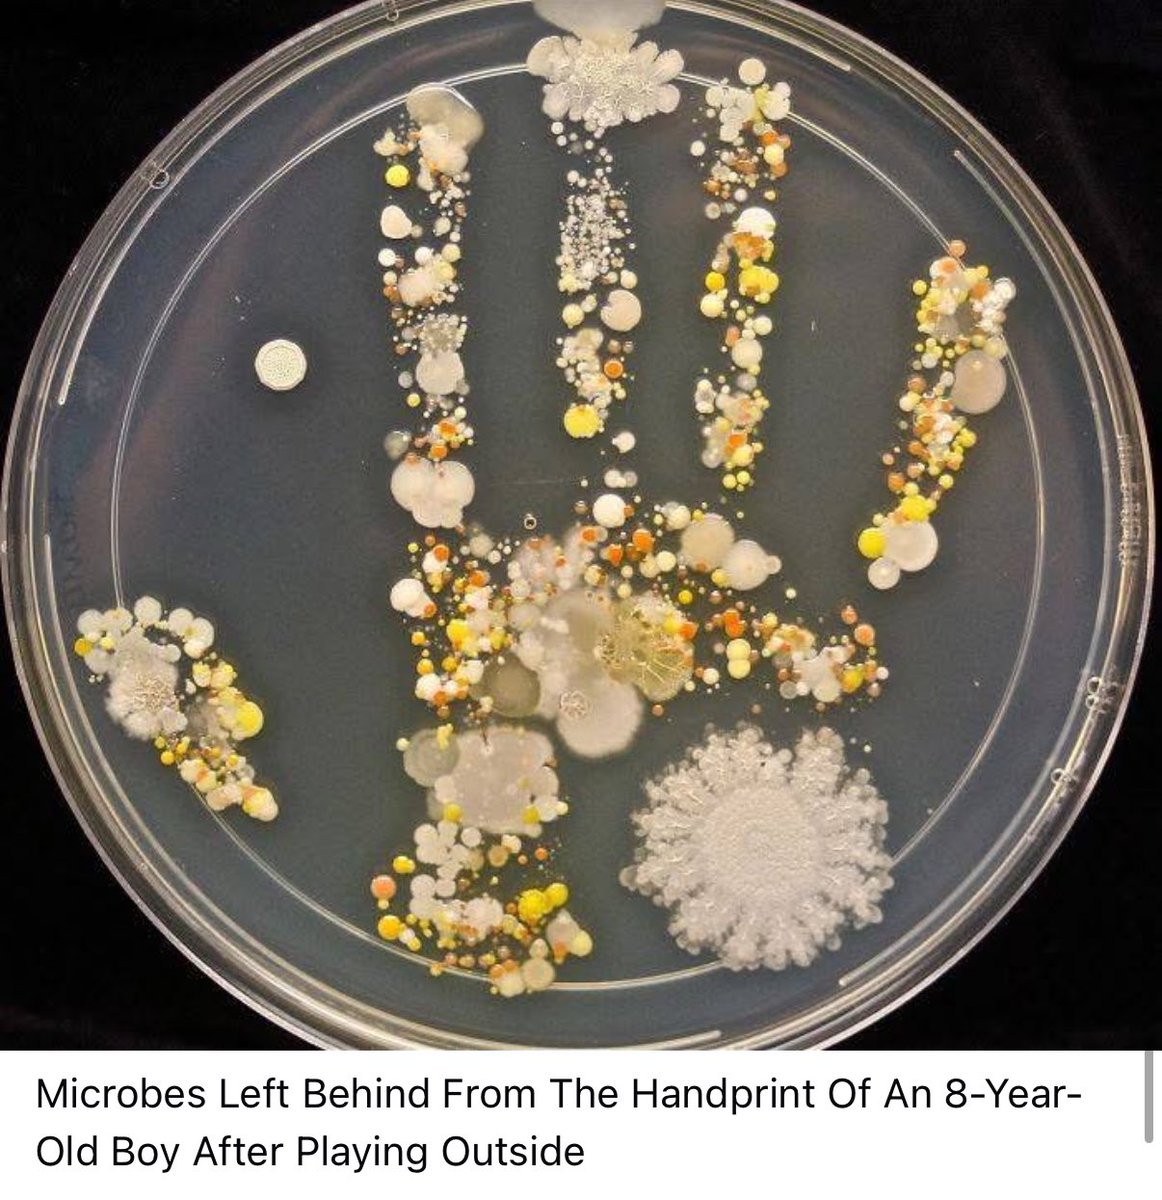
imkongla's tweet image. Imagine that!

Imkongla Jamir
@imkongla
Civil Servant, Music, Miniatures, Nature, Books and Food . Chevening Gurukul Fellow 2024. Views personal.
You might like
Hmmmmmm…
The jail hopefully isn’t AI!
UP is not for beginners A joke gone wrong! 😅 A man from Lucknow edited his photo with AI to add a leopard and posted it online saying, “Spotted in my area.” The post went viral, people panicked, and even the forest department rushed in — only to find it was fake. Now, he’s in…

The corner patch I started from scratch! ( but for the tree)

Oooooh to be there and witness it!!!❤️
Freddie is looking down and giving y'all a standing ovation. That's spectacular!😍💗 The most INSANE Bohemian Rhapsody Flashmob you will ever see!! With 30 musicians and singers in the STREET of Paris 😍 Cre : Julien Cohen Pianist
A beautiful day highlighted by a visit to the National War Memorial.

Happy to be back where #CheveningGurukulFellowship 2024 began a year ago!
There’s an exciting energy in a room full of returning #Cheveners. These @CheveningFCDO alumni are ready to shape what comes next for India and the 🇬🇧-🇮🇳 relationship. Welcome home, future leaders!

My roots. My Chungtia! @RajeevRC_X @Hekani @sashiwapang
Hats off to @ariez_jamz and the IO/KI team for this short and insightful aftermovie of the 2025 Moatsü festival in Chungtia village! youtu.be/E9KVbbf1JYg?si… @ningsangjamir @imkongla @travel_the_worl

youtube.com
YouTube
The Moatsü Festival Chungtia 2025 Aftermovie
The Phantom Warrior of Assam Rifles @official_dgar — Havildar Mering Ao, SC (Retd) Born 15 Nov 1920 | 3rd Battalion, The Assam Rifles | WWII Veteran (Kohima & Burma) | Shaurya Chakra awardee Not every hero is in our textbooks. Some live on as quiet legends — remembered by their…

Here's my 2024 Twitter Wrapped! twitterwrapped.exa.ai/imkongla?share x.com/ExaAILabs/stat…
See your 2024 Twitter Wrapped! Exa-powered AI finds your favorite topics, top tweets, and even whether you’ve been naughty/nice 😈 Get yours here - twitterwrapped.exa.ai
United States Trends
- 1. Happy Thanksgiving Eve 1,639 posts
- 2. Good Wednesday 22.1K posts
- 3. Luka 66K posts
- 4. #DWTS 97.7K posts
- 5. Lakers 51.6K posts
- 6. Clippers 19.1K posts
- 7. Robert 142K posts
- 8. Kris Dunn 2,933 posts
- 9. Collar 46.7K posts
- 10. Jim Mora 1,070 posts
- 11. #LakeShow 3,606 posts
- 12. Kawhi 6,581 posts
- 13. Karoline Leavitt 25.1K posts
- 14. Colorado State 2,702 posts
- 15. Alix 15.3K posts
- 16. Jaxson Hayes 2,657 posts
- 17. Reaves 13.8K posts
- 18. TOP CALL 14.8K posts
- 19. Elaine 46.6K posts
- 20. Ty Lue 1,682 posts
You might like
-
 abhishek singh
abhishek singh
@abhish18 -
 IAS Association
IAS Association
@IASassociation -
 Sajjan Yadav IAS
Sajjan Yadav IAS
@Sajjan95 -
 Hekani Jakhalu
Hekani Jakhalu
@JakhaluHekani -
 Limabenla Jamir
Limabenla Jamir
@LimabenJamir -
 Awanish Sharan 🇮🇳
Awanish Sharan 🇮🇳
@AwanishSharan -
 TN Elections CEO
TN Elections CEO
@TNelectionsCEO -
 Pavan Agarwal
Pavan Agarwal
@PavanAgarwal15 -
 Supriya Sahu IAS
Supriya Sahu IAS
@supriyasahuias -
 Param Iyer
Param Iyer
@paramiyer_ -
 Vijayakarthikeyan K
Vijayakarthikeyan K
@Vijaykarthikeyn -
 Susanta Nanda IFS (Retd)
Susanta Nanda IFS (Retd)
@susantananda3 -
 Shahid Choudhary
Shahid Choudhary
@listenshahid -
 P Narahari IAS
P Narahari IAS
@pnarahari -
 Ajay Kumar
Ajay Kumar
@drajaykumar_ias
Something went wrong.
Something went wrong.